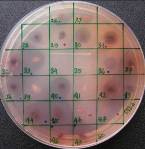

実施概要
背景 / 調査の目的
マレー半島とスマトラ島の間のマラッカ海峡は、中東、欧州等と東アジアを結ぶ海上輸送路の要衝でありますが、狭く浅瀬が多い上に1日数十隻もの大型タンカーが行き交う海の難所でもあり、航行過密による接触事故や海洋汚染が懸念されています。実際、マラッカ海峡ではオイルタンカー衝突事故がしばしば起こります。例えば、1975年、22万4千トンの原油を満載してペルシア湾から日本に向けて航行していた太平洋海運(株)所属のマンモスタンカー、祥洋丸がマラッカ海峡とシンガポール海峡の接続点付近で座礁し、約4,500キロリットルの原油が流出しました。流出事故が起きればインドネシアはその被害者となります。大型タンカーのマラッカ海峡通過は危険であると警告していたインドネシア政府は、日本に補償を請求しました。マラッカ海峡ではこの後、川崎汽船(株)のタンカーとリベリア船籍のタンカーの接触事故も起きています。
【図1】ロンボク海峡、マラッカ・シンガポール海峡は、
幅が狭いにも関わらず多くのタンカーが行き来しています

マラッカ海峡経由以外にもいくつかのオイルロードがありますが、いずれもインドネシア沿岸を走っています。例えば、30万トン以上で原油を運搬するタンカーはマラッカ海峡を通航不可能であるため、ロンボク海峡を常用航路としています。このロンボク海峡はマラッカ海峡閉鎖時のう回路として想定されていますが、分離通航方式及び船舶交通情報等が未整備であり、レーダーや航路標識のような航行援助施設・設備についても十分とはいえません。したがって、マラッカ海峡閉鎖時にマラッカ海峡を航行する船舶がロンボク海峡へう回した場合、船舶の集中による石油流出事故等の発生が懸念されています。
石油流出事故の対策の一つとして、微生物を用いた浄化(バイオレメディエーション)があります。この技術は、アラスカの石油流出事故の際、大々的に使用されました。その後、いくつかの研究が行われていますが、まだ一般的技術として普及するに至っていません。海洋における原油流出事故のたびに、バイオレメディエーション適用可能性が議論されますが、その有効性に関する情報が少ないため、迅速かつ的確な対策がとれない場合が多いです。原油流出事故が起こる可能性の高い海域については、バイオレメディエーションに関する基礎情報、例えば、現場海域に存在する石油分解菌やその分解力について、あらかじめ調査を実施しておくことは、危機管理の観点から重要です。
日本向け石油の輸送経路については、マラッカ海峡とロンボク海峡の2地点における石油流出事故の発生を想定して、バイオレメディエーション適用可能性を明らかにしておく必要があります。これらインドネシア海域で原油流出事故による汚染が起こり、その汚染をバイオレメディエーションによって浄化できるか否かを判断するためには、当該海域にどのような分解微生物が生息し、どのような条件でどの程度の分解能力を発揮するのかを知る必要があります。しかし、インドネシアを含む熱帯海域でのバイオレメディエーション実施例や分解細菌の分離例等は今まで存在せず、不明な点が多くありました。本調査は、このような背景から実施されました。
本調査をインドネシア国内で実施するに当たっては、日本では想定し得ない様々な問題に遭遇しました。特筆すべきは、現地の実験環境の整備に多大の努力を必要としたこと、そして、現地で分離した石油分解菌を日本に移転するため、生物多様性条約を遵守した二国間の取り決めの交渉を必要としたことです。関係者の努力によって、このような問題を乗り越えて、当初の目標を達成できました。
本調査に協力したインドネシア科学院(LIPI)の研究員からは、この調査に参加できたことに対する大きな感謝の意が表されました。オイルロードのあい路に位置し、石油資源の国際輸送上重要なこの国との交流・友好にも貢献できたものと自負しています。
実施概要
本調査は以下のような流れで行いました。
- 石油分解菌の検出とその多様性
- インドネシア海域において、自然海水中の細菌の群集構造の解析し、原油及び栄養塩存在下、すなわち、バイオスティミュレーション条件下において、どのような石油分解菌が優占化するかを調べました。
- 石油分解遺伝子の多様性
- 三つの方法を用いて石油分解菌を分離しました。16S rRNA遺伝子配列に基づく系統解析により分類し遺伝子の多様性を調べました。
- 石油分解菌の特性の解明
- 代表的な石油分解遺伝子について、石油炭化水素の分解能力を調査しました。
- 石油分解菌を活性化する条件の検討
- バイオスティミュレーションの最適化を目指し、緩効性肥料の選択、肥料の添加量と添加時期等の検討を行いました。
調査の方法
| インドネシア及び日本の海から微生物を採取 |
|---|

| 採取したサンプル内の多様な微生物群から、石油分解菌を単離 | 原油を唯一の炭素減として加えた培地で、石油分解菌の集積培養(目的とする微生物を単離するための培養方法)を行いました。これによりインドネシア海水中に生息する多種類の微生物の中から、石油分解菌のみを単離することができます。
【図5】原油を分解する微生物
![]() 【図6】原油を含んだ培地での集積培養
![]()
|
|---|

| 各種炭化水素を用いた分解菌の単離 | 分離した石油分解菌群を、各種の炭化水素を用いて分離しました。それぞれの菌が分解できる炭化水素の種類ごとに、石油分解菌を単離することができます。
用いた石油系炭化水素の種類
石油分解菌の分離法
【図7】各種炭化水素を用いた分解菌の単離
![]() 【図8】ジベンゾチオフェン分解菌
![]() ジベンゾチオフェンを塗ってある箇所は白く濁って見えます。 しかし、分解菌が増えた箇所はジベンゾチオフェンが分解され透明になっています。 |
|---|

| 単離菌株の系統学的同定 | 16 S rDNA 塩基配列による同定
【図9】原油分解菌
![]() |
|---|---|
| 機能解析 |
|
| 活性化条件検討(海浜模擬実験) |
【図10】PCR スクリーニング
![]() 【図11】GC / MS 分析
![]() |
- 実施概要
- 石油分解菌の検出とその多様性
- 石油分解遺伝子の多様性
- 石油分解菌の特性の解明
- 石油分解菌を活性化する条件の検討
- 収集した菌株の提供
お問い合わせ
- 独立行政法人製品評価技術基盤機構 バイオテクノロジーセンター バイオ技術評価・開発課(かずさ)
-
TEL:0438-20-5764
住所:〒292-0818 千葉県木更津市かずさ鎌足2-5-8 地図
お問い合わせフォームへ